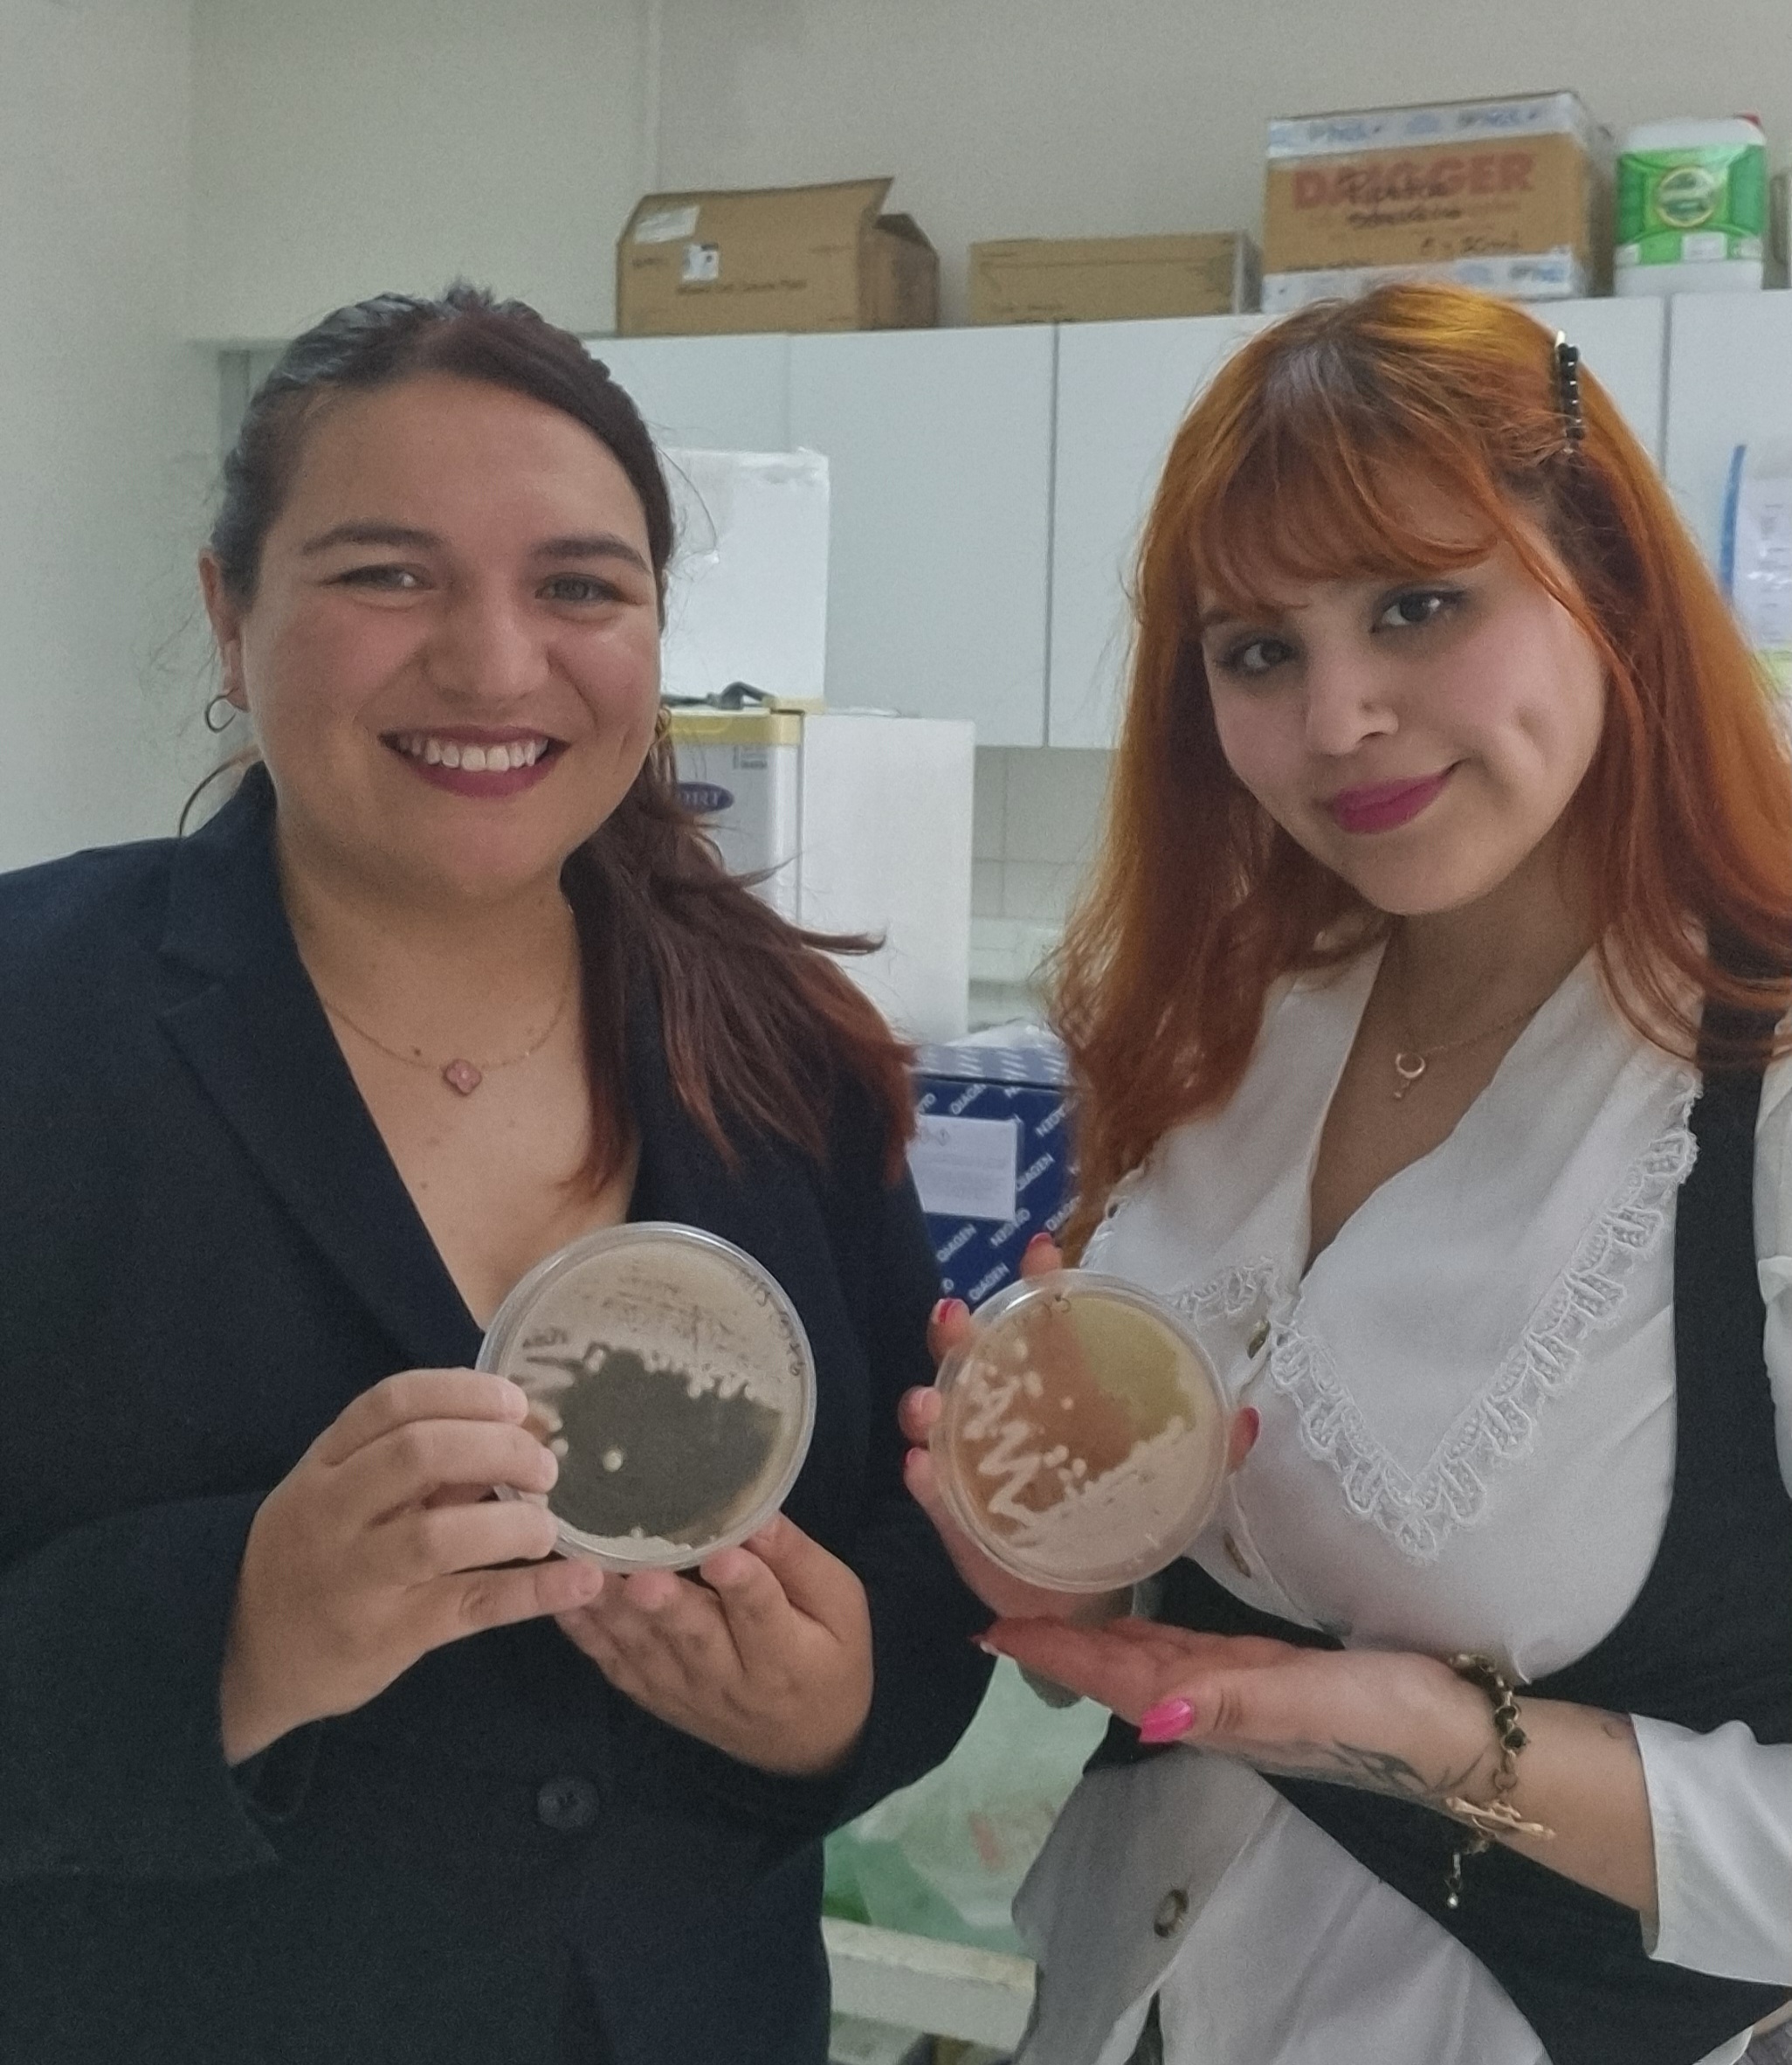

Proyectos universitarios fueron reconocidos en la nueva edición del concurso YA!-e
Cuatro iniciativas fueron seleccionadas como ganadoras del concurso interno YA!-e, organizado por INNOVA UNAP y la Vicerrectoría de Investigación e Innovación, que busca fomentar el desarrollo de proyectos de innovación aplicada en etapas tempranas, otorgando financiamiento, mentorías académicas y formación en innovación a estudiantes de pre y posgrado.

El concurso YA!-e, impulsado por INNOVA UNAP y la Vicerrectoría de Investigación e Innovación, premió a cuatro proyectos que destacan por su creatividad, rigor científico y potencial de impacto en los ámbitos agrícola, biotecnológico y alimentario del norte de Chile. La iniciativa entrega hasta un millón de pesos por proyecto, acompañamiento académico y capacitación en innovación, con el objetivo de preparar a los estudiantes para futuras postulaciones a fondos como el VIU 2026 de ANID.
El 1º lugar fue obtenido por Michelle Cifras Céspedes, estudiante de Ingeniería en Biotecnología, junto a su profesora guía Lía Ramírez Fernández, con el proyecto “Levaduras nativas de la Pampa del Tamarugal”, que explora microorganismos autóctonos del desierto para identificar cepas con potencial en la vitivinicultura del norte de Chile, fortaleciendo el concepto de terroir microbiano regional.
El 2º lugar recayó en Maite Andrea Villalobos Pérez, también de Ingeniería en Biotecnología, junto al académico Alexis Velásquez, con el proyecto “AYNIMIC: bioestimulante a base de hongos micorrícicos nativos del desierto de Tarapacá”. La propuesta busca desarrollar un bioestimulante que mejore la productividad agrícola en suelos desertificados, mediante hongos adaptados al estrés abiótico, con enfoque en sostenibilidad y aplicación territorial.

El 3º lugar fue para Sebastián Sepúlveda Villegas, estudiante del Magíster en Ciencias Químicas y Farmacéuticas, guiado por la profesora Karina Ruiz Carrasco, con el proyecto “Validación de un bioestimulante basado en saponinas de quinoa tarapaqueña”. La investigación propone aprovechar subproductos del cultivo de quinoa en un modelo de economía circular, para fortalecer la tolerancia de plantas al estrés salino y aportar al desarrollo de bioinsumos ecológicos aplicables en la agricultura del norte del país.

Finalmente, el 4º lugar lo obtuvo Cristofer Ignacio Gaete Collao, de Ingeniería en Biotecnología, junto al Dr. Lucas Patricio Hernández Saravia, con el proyecto “Sensor inteligente para inocuidad alimentaria: detección electroquímica de nitritos en carnes procesadas”. La iniciativa desarrolla un sensor ecológico y de bajo costo, basado en nanopartículas sintetizadas con cáscaras de mango, que permite detectar compuestos potencialmente dañinos en alimentos, aportando a la seguridad y sostenibilidad alimentaria.

Al respecto, Raúl Castillo, director de Innovación de la UNAP, destacó que “INNOVA UNAP cumple un rol fundamental en el impulso de una cultura de innovación dentro de la universidad. A través de programas como YA!-e, apoyamos a los estudiantes para que transformen sus ideas en proyectos concretos con impacto real, fortaleciendo sus capacidades y generando soluciones desde el territorio para el territorio”.
Estos estudiantes y sus profesores fueron reconocidos durante la reciente Semana de la Ciencia UNAP 2025, organizada por la Vicerrectoría de Investigación e Innovación y realizada en el Hotel NH Iquique. En la ceremonia, se valoró el trabajo colaborativo entre estudiantes y académicos, buscando visibilizar sus aportes al desarrollo científico regional e incentivarles a continuar fortaleciendo sus proyectos
Con estos resultados, YA!-e consolida su propósito de promover una cultura de innovación universitaria desde etapas tempranas, fortaleciendo la investigación y el talento científico de la UNAP.






ETIQUETAS DE LA NOTICIA



